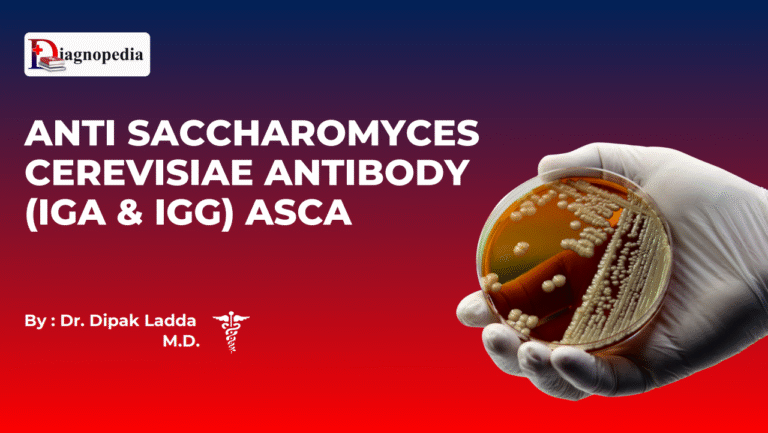
Anti Saccharomyces Cerevisiae Antibody (IgA & IgG) ASCA

Library
Explore curated doctoral theses and clinical presentations— organized for clarity, built for quick reference, and trusted by the medical community.
Start Exploring 850+ Medical Topics
Ex: Cholesterol
Featured Topics

Overview The document describes Anti Thrombin III (AT III) as a naturally occurring anticoagulant protein belonging to the serine protease...

Overview Anti Sperm Antibody (ASA) is an immunological factor that contributes to infertility when the body mistakenly identifies sperm as...

Overview Anti-Soluble Liver Antigen (Anti-SLA) antibodies are immune proteins directed against soluble liver antigens, specifically targeting the UGA tRNA-associated antigen...
Overview Anti Saccharomyces Cerevisiae Antibody (ASCA) refers to immune proteins (IgA and IgG classes) directed against antigens found in the...

Overview The ACCP (Anti-Cyclic Citrullinated Peptide) antibody test is a highly specific serologic marker used to support the diagnosis, prognosis...












